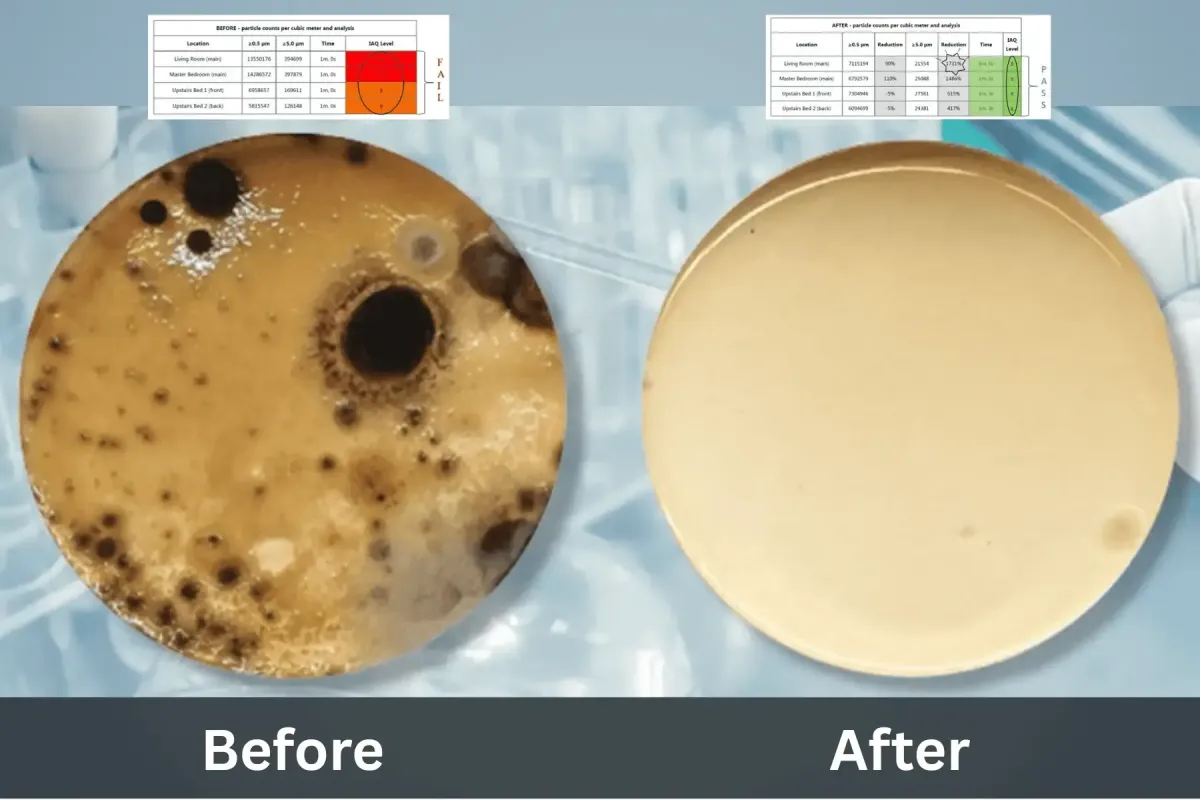
Before and after photo of mold spores in petri dish

➤ (888) 928-6653 ____ ➤ Schedule Inspection
Before and After Photos
ZeroMold is built on results you can see and trust. Since the beginning, we’ve helped customers take control of mold issues using a proven, professional approach. Explore the transformations made possible by our experienced team as we return homes and workplaces to clean, healthy conditions.

Proven Experience


Let's get started
Copyright © 2026 ZeroMold. All Rights Reserved - Privacy Policy - Terms & Conditions